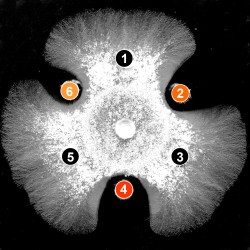
発酵・生命科学コース

亜熱帯生物資源科学科
Bioscience and Biotechnology

亜熱帯の沖縄は生物資源と食資源の宝箱。私たちと一緒に宝探しの旅に出よう!
医薬品・食品・発酵の技術開発が原石を宝石に変える!
バイオ・ヘルスサイエンスで切り拓く健康長寿社会の実現!
亜熱帯地域に生息する動植物および微生物などの生物資源および伝統食品・発酵食品・その他食資源の特性や機能性を、遺伝子工学・生化学・物理化学・生理学・栄養学および調理学的な解析により明らかにします。それらの知見をもとにバイオテクノロジーによる新規有用物質の生産、機能性食品、発酵食品、医農薬品などに利用可能な成分の開発を行います。さらに農学の幅広い知識と地域特性を理解した栄養士の養成を通じて豊かで健康的な生活・長寿社会の構築に貢献していきます。
動画で見る
亜熱帯生物資源科学科 紹介動画
教育・研究目標
- 微生物と動植物起源の生理活性物質や機能性生体成分の構造解析と高度利用
- 地域生物資源からの機能性食品や健康食品の開発
- 生物工学的技術による新規な生物機能の開発と高度利用
- 伝統的発酵食品の高品質化と新しい発酵食品の開発
- 郷土の食文化を栄養学的に解明し、健康的な長寿社会の構築に貢献
求める学生像
- 生物資源の利用・開発およびバイオテクノロジーに関心のある人
- 健康の保持増進に有効な機能性食品の開発に興味を持つ人
- 発酵科学を通じて食品・医薬産業に貢献したい人
- 栄養学・食育を通じて地域社会の健康の保持増進に貢献したい人(健康栄養科学コースのみ)
教育コース

生物機能開発学コース
亜熱帯の生物資源の機能特性を分子から生体レベルで追求し、人類の福祉に有効な機能性素材の開発や利用に関する専門的知識の修得
主な専門科目
- 生理活性物質学
- 遺伝子工学
- 生物資源利用学
- 天然物化学
- 糖鎖生命科学
- 生物工学
学びのキーワード
- #多糖類の構造と機能
- #生物活性物質の解析
- #機能性素材の開発

食品機能科学コース
食品の機能性を健康維持、増進の観点から追求し、新たな食品素材を開発すると共に、健康生活の向上に関する専門的知識の修得
主な専門科目
- 食品利用加工学
- 栄養生理学
- 食品機能化学
- 食品衛生学
学びのキーワード
- #食品成分の分析
- #食品の利用と加工
- #健康の増進

発酵・生命科学コース
地域特性を生かした発酵食品の開発、ならびに亜熱帯生物資源の生命現象の解析とその応用に関する専門的知識の修得
主な専門科目
- 発酵化学
- 泡盛釀造学
- 生命科学
- 応用酵素学
- 微生物機能学
- タンパク質工学
学びのキーワード
- #発酵微生物
- #バイオテクノロジー
- #ライフサイエンス

健康栄養科学コース
人間栄養学の観点から食を科学的かつ実践的に捉え、地域の特性を考慮した健康・長寿社会の実現に関する専門的知識の修得
主な専門科目
- 調理学
- 栄養指導論
- ライフステージ栄養学
- 給食管理
- 臨床栄養学
- 公衆栄養学
学びのキーワード
- #栄養
- #健康
- #食育
カリキュラム
1年次
教養•基礎
幅広い教養を身につける共通教育、専門科目の基礎となる専門基礎科目を修得します
- 共通教育科目
- 学部共通科目
(亜熱帯農学の理念を修得) - 専門基礎教育科目
2年次
学科基礎
学科基礎科目を受講することで、学科の理念を修得します
- 有機化学
- 物理化学
- 分子生物学
- 食品科学
- 微生物機能学
3年次
教育コース
興味、必要な資格に応じた教育コースを選択し、専門科目を修得します
- 生物機能開発学コース
- 食品機能科学コース
- 発酵・生命科学コース
- 健康栄養科学コース
4年次
専門分野配属
基礎から応用までを修得した専門分野を卒業研究として自ら総括します
- 卒業論文Ⅰ・Ⅱ
想定される就職先
- 発酵・醸造分野の技術者
- 地方・国家公務員
- 食品製造技術者
- バイオテクノロジー技術者
- 病院・福祉施設・学校給食施設・保育園
- 医薬関連産業・化粧品関連産業従事者
- 農芸化学分野の技術者
- 行政(市村役場等)
資格・免許
健康栄養科学コースを除く3コースの学生を対象
教職免許
- 高等学校教諭一種免許状〔農業]
任用資格
- 食品衛生管理者
- 食品衛生監視員
- 環境衛生監視員
受験資格
- 上級バイオ技術者
- 健康食品管理士
- 危険物取扱者(甲種)
資格
- 毒物劇物取扱責任者
健康栄養科学コースの学生を対象
免許
- 栄養士
教職免許
- 栄養教諭二種免許状
- 高等学校教諭一種免許状〔農業〕
受験資格
- 管理栄養士*
*栄養土免許を取得後、実務経験(1年以上)を必要とする受験資格
- 健康食品管理士
コース担当教員
| 生物機能開発学 |
小西 照子
Teruko Konishi |
教授 | 植物生理学 /応用生物化学 | 多糖類機能化学研究室 |
|---|---|---|---|---|
| 生物機能開発学 |
金子 哲
Satoshi Kaneko |
教授 | 農学 /森林圏科学 /木質科学 | 糖鎖科学研究室 |
| 生物機能開発学 |
石井 貴広
Takahiro Ishii |
教授 | 天然物科学 /生物活性物質学 /水産化学 /農薬化学 /創薬化学 /化学生態学 | 生物活性物質学研究室 |
| 生物機能開発学 |
福田 雅一
Masakazu Fukuta |
准教授 | 分子生物学 | 遺伝子工学研究室 |
| 食品機能科学 |
高良 健作
Kensaku Takara |
教授 | 食品化学 | 食品化学研究室 |
|---|---|---|---|---|
| 食品機能科学 |
稲福 征志
Masashi INAFUKU |
准教授 | 栄養生化学 /食品機能学 /ライフサイエンス | 食資源利用学研究室 |
| 食品機能科学 |
高橋 誠
Makoto Takahashi |
准教授 | 食品化学 /食品加工学 /食品機能学 /オレオサイエンス(ナノ材料学) /マリンサイエンス(水産養殖・加工学) | 食品利用加工学研究室 |
| 食品機能科学 |
Yonathan Asikin
Yonathan Asikin |
准教授 | 食品科学 /食品成分化学 /フレーバー分析 | 食品化学研究室 |
| 健康栄養科学 |
橘 信二郎
TACHIBANA Shijnjiro |
准教授 | 発酵学 /食品科学 /応用酵素学 /微生物利用学 | 微生物利用学研究室 |
|---|---|---|---|---|
| 健康栄養科学 |
大西 竜子
Ryuko Ohnishi |
准教授 | 栄養学 /応用健康科学 | 栄養学研究室 |
| 健康栄養科学 |
宮城 一菜
Kazuna Miyagi |
准教授 | 食品学 /栄養指導 / | 食品・栄養指導研究室 |
| 健康栄養科学 |
井口 直子
Naoko Iguchi |
准教授 | 食育 /給食管理 /調理 | 給食管理・食育研究室 |